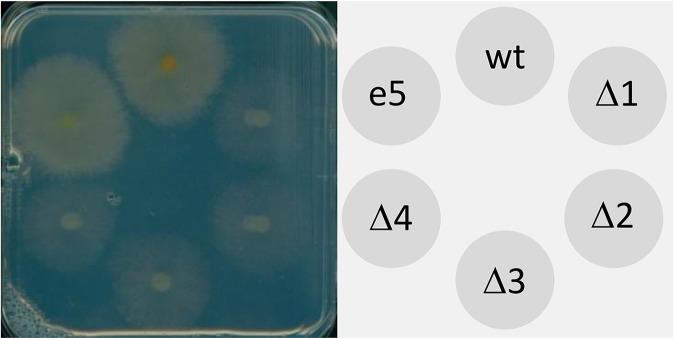
https://cdn.ncbi.nlm.nih.gov/pmc/blobs/48fc/6746940/92a1cdcd5092/fpls-10-01072-g005.jpg

候选 ACC 脱氨酶的生化特性及基因敲除突变株的毒力测试
Biochemical Characterization of the Candidate ACC-Deaminases and Virulence Testing of Knockout Mutant Strains.
作者信息
Svoboda Thomas, Parich Alexandra, Güldener Ulrich, Schöfbeck Denise, Twaruschek Krisztian, Václavíková Marta, Hellinger Roland, Wiesenberger Gerlinde, Schuhmacher Rainer, Adam Gerhard
机构信息
Department of Applied Genetics and Cell Biology, University of Natural Resources and Life Sciences, Vienna (BOKU), Tulln, Austria.
BOKU, Department for Agrobiotechnology (IFA-Tulln), Institute of Bioanalytics and Agro-Metabolomics, Tulln, Austria.
出版信息
Front Plant Sci. 2019 Sep 10;10:1072. doi: 10.3389/fpls.2019.01072. eCollection 2019.
is a plant pathogenic fungus which is able to infect wheat and other economically important cereal crop species. The role of ethylene in the interaction with host plants is unclear and controversial. We have analyzed the inventory of genes with a putative function in ethylene production or degradation of the ethylene precursor 1-aminocyclopropane carboxylic acid (ACC). , in contrast to other species, does not contain a candidate gene encoding ethylene-forming enzyme. Three genes with similarity to ACC synthases exist; heterologous expression of these did not reveal enzymatic activity. The genome contains in addition two ACC deaminase candidate genes. We have expressed both genes in and characterized the enzymatic properties of the affinity-purified products. One of the proteins had indeed ACC deaminase activity, with kinetic properties similar to ethylene-stress reducing enzymes of plant growth promoting bacteria. The other candidate was inactive with ACC but turned out to be a d-cysteine desulfhydrase. Since it had been reported that ethylene insensitivity in transgenic wheat increased resistance and reduced the content of the mycotoxin deoxynivalenol (DON) in infected wheat, we generated single and double knockout mutants of both genes in the strain PH-1. No statistically significant effect of the gene disruptions on fungal spread or mycotoxin content was detected, indicating that the ability of the fungus to manipulate the production of the gaseous plant hormones ethylene and HS is dispensable for full virulence.
是一种植物病原真菌,能够感染小麦和其他具有重要经济价值的谷类作物品种。乙烯在与宿主植物相互作用中的作用尚不清楚且存在争议。我们分析了在乙烯产生或乙烯前体1-氨基环丙烷羧酸(ACC)降解中具有推定功能的基因清单。与其他物种相比,不包含编码乙烯形成酶的候选基因。存在三个与ACC合酶相似的基因;这些基因的异源表达未显示出酶活性。该基因组还包含两个ACC脱氨酶候选基因。我们在中表达了这两个基因,并对亲和纯化产物的酶学性质进行了表征。其中一种蛋白质确实具有ACC脱氨酶活性,其动力学性质与促进植物生长细菌的乙烯应激降低酶相似。另一个候选基因对ACC无活性,但结果是一种d-半胱氨酸脱硫酶。由于有报道称转基因小麦中的乙烯不敏感性增加了抗性并降低了受感染小麦中霉菌毒素脱氧雪腐镰刀菌烯醇(DON)的含量,我们在菌株PH-1中产生了这两个基因的单敲除和双敲除突变体。未检测到基因破坏对真菌传播或霉菌毒素含量有统计学上的显著影响,这表明该真菌操纵气态植物激素乙烯和硫化氢产生的能力对于完全致病性是可有可无的。